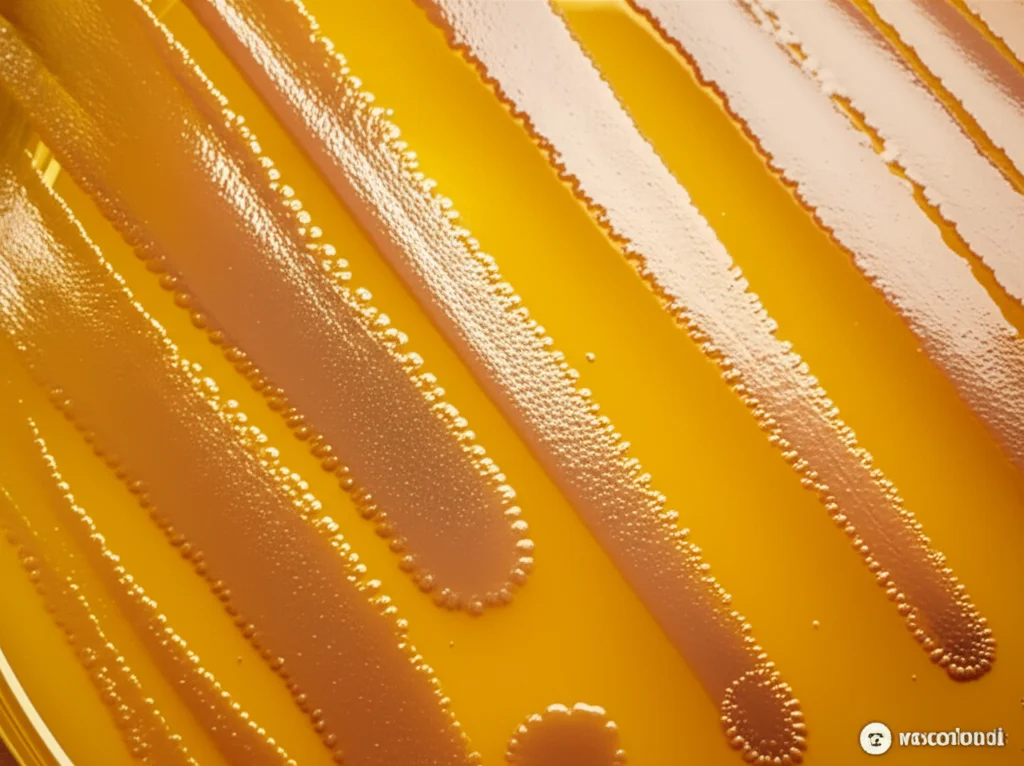
Macro fotografia di diverse colonie batteriche colorate e morfologicamente distinte su una piastra di Petri, vista dall'alto, lente macro 100mm, alta definizione dei dettagli, illuminazione controllata da laboratorio che enfatizza le texture delle colonie, focus selettivo.

Intestino, Fegato, Reni: Un Legame Inaspettato Svelato dal Microbiota
Ciao a tutti! Oggi voglio portarvi con me in un viaggio affascinante all’interno del nostro corpo, un luogo dove organi apparentemente distanti comunicano in modi sorprendenti. Parleremo di fegato, reni e, soprattutto, dell’incredibile mondo dei microbi che popolano il nostro intestino: il microbiota intestinale.
Forse avrete sentito parlare di MASLD (Malattia Steatosica Epatica Associata a Disfunzione Metabolica), quello che una volta chiamavamo fegato grasso non alcolico. È una condizione diffusissima, che colpisce quasi un terzo della popolazione mondiale! E poi c’è la CKD (Malattia Renale Cronica), un’altra preoccupazione sanitaria globale che interessa oltre il 10% delle persone. Entrambe sono considerate malattie “multisistema”, con impatti che vanno ben oltre l’organo primario, influenzando cuore, metabolismo e aumentando il rischio di altre patologie.
La cosa intrigante? Queste due condizioni, MASLD e CKD, sono spesso legate. Chi soffre di MASLD ha un rischio significativamente più alto di sviluppare problemi renali. Ma perché? Certo, condividono fattori di rischio come diabete, obesità, pressione alta… ma c’è di più sotto la superficie. E qui entra in gioco il nostro protagonista silenzioso: il microbiota intestinale.
L’Intestino al Centro della Scena: Disbiosi e Barriera Compromessa
Sempre più studi indicano che l’intestino non è solo un tubo per la digestione. È un ecosistema complesso, e i suoi abitanti – miliardi di batteri, funghi e virus – insieme ai loro prodotti (i metaboliti, come gli acidi grassi a catena corta – SCFA) giocano un ruolo cruciale nella nostra salute. Esistono vere e proprie “autostrade” di comunicazione tra l’intestino e altri organi: l’asse intestino-fegato e l’asse intestino-rene.
Quando l’equilibrio di questo ecosistema si rompe – parliamo di disbiosi intestinale – e quando la parete dell’intestino diventa più permeabile (il famoso “leaky gut” o intestino permeabile), le cose iniziano ad andare storte. Tossine e frammenti batterici possono passare nel sangue, scatenando infiammazione sistemica e influenzando organi lontani, come fegato e reni.
Ecco perché ci siamo chiesti: come cambia esattamente il microbiota intestinale in chi soffre di MASLD rispetto a chi ha la CKD? E cosa succede a chi, purtroppo, le ha entrambe? C’erano pochi dati comparativi diretti, così abbiamo deciso di indagare.
Il Nostro Studio Comparativo: Cosa Abbiamo Trovato?
Abbiamo coinvolto un bel gruppo di persone: 22 controlli sani e 180 pazienti divisi tra MASLD (90), CKD (60) e un gruppo con entrambe le malattie (30), facendo attenzione che fossero simili per età e sesso. Abbiamo analizzato campioni di feci per “leggere” il DNA dei batteri presenti (sequenziamento del gene 16S rRNA) e misurato l’espressione di un gene chiave per la produzione di butirrato (uno degli SCFA più importanti), il BCoAT (Butirril-CoA:acetato CoA transferasi). Inoltre, abbiamo cercato nel sangue un marcatore di danno alla barriera intestinale, la proteina I-FABP (Intestinal Fatty Acid Binding Protein).
I risultati sono stati illuminanti!
- Diversità batterica: Rispetto ai sani, chi aveva la MASLD mostrava una chiara alterazione sia nella ricchezza (quanti tipi diversi di batteri) sia nella composizione generale del microbiota (alpha e beta diversità). Nei pazienti con CKD, invece, abbiamo notato differenze significative soprattutto nella composizione generale (beta diversità), ma non sempre nella ricchezza (alpha diversità).
- Batteri “buoni” in calo: Sia nel gruppo MASLD che in quello CKD, abbiamo osservato una riduzione di batteri noti per produrre SCFA benefici, in particolare il genere Bifidobacterium. Pensate che nei sani questi batteri erano molto più abbondanti!
- Batteri “cattivi” e differenze specifiche: Confrontando MASLD e CKD direttamente, sono emerse differenze nette. I pazienti con CKD avevano una maggiore presenza di batteri potenzialmente patogeni. Generi come Ruminococcus gnavus, Lachnoclostridium ed Escherichia Shigella erano più dominanti nei gruppi di pazienti rispetto ai sani.
Butirrato e Barriera Intestinale: Segnali d’Allarme nella CKD
Qui le differenze si sono fatte ancora più marcate.
- Produzione di Butirrato (BCoAT): I livelli di BCoAT nelle feci erano significativamente più bassi nei pazienti con CKD e in quelli con entrambe le malattie, rispetto sia ai controlli sani che ai pazienti con solo MASLD. Questo suggerisce una ridotta capacità del loro microbiota di produrre questo fondamentale acido grasso. Inoltre, abbiamo visto che più bassi erano i livelli di BCoAT, peggiore era la funzione renale (misurata come eGFR) e più alti erano i livelli di I-FABP (il marcatore di danno intestinale). Una correlazione inversa molto interessante!
- Integrità della Barriera (I-FABP): I livelli di I-FABP nel sangue erano alle stelle nei pazienti con CKD, molto più alti rispetto ai sani e anche rispetto a chi aveva solo la MASLD. Anche chi aveva entrambe le malattie mostrava livelli elevati, simili a quelli della CKD. Questo indica un danno significativo alla barriera intestinale, soprattutto nella malattia renale. E, come previsto, alti livelli di I-FABP erano associati a una peggiore funzione renale.
Sembra quasi un circolo vizioso nella CKD: la malattia renale peggiora la disbiosi e la permeabilità intestinale, e queste a loro volta contribuiscono al danno renale e all’infiammazione sistemica.
Identikit Batterico: Distinguere MASLD da CKD
Le differenze nella composizione batterica a livello di genere erano così specifiche che, utilizzando un’analisi statistica (Random Forest), siamo riusciti a creare un “identikit” batterico capace di distinguere i pazienti con MASLD da quelli con CKD con un’accuratezza notevole (AUC di 0.90)! Questo ci dice che, sebbene ci siano delle sovrapposizioni, i profili di disbiosi in queste due condizioni sono distinti.
Ad esempio, nei pazienti con CKD erano più abbondanti generi noti per produrre tossine uremiche (come Escherichia_Shigella, Collinsella) che peggiorano la funzione renale. Alcuni di questi, come Collinsella, erano anche correlati a una peggiore funzione renale (eGFR più basso) e, curiosamente, anche alla gravità del fegato grasso (misurata con il CAP score).

E Chi Ha Entrambe le Malattie? Un Quadro Misto
Il gruppo di pazienti con sia MASLD che CKD presentava un quadro affascinante e complesso. La loro disbiosi intestinale mostrava caratteristiche un po’ dell’una e un po’ dell’altra malattia a livello di composizione batterica. Tuttavia, per quanto riguarda la ridotta produzione di butirrato (basso BCoAT) e l’aumentata permeabilità intestinale (alto I-FABP), questi pazienti assomigliavano molto di più a quelli con la sola CKD. Questo suggerisce che, quando le due condizioni coesistono, l’impatto sulla capacità di produrre butirrato e sull’integrità della barriera intestinale potrebbe essere guidato principalmente dalla componente renale.
Perché Tutto Questo è Importante?
Capire queste differenze e somiglianze nella disbiosi intestinale tra MASLD e CKD apre scenari interessanti. Non abbiamo ancora cure farmacologiche risolutive per queste malattie, spesso ci si affida a modifiche dello stile di vita. Ma questi dati rafforzano l’idea che intervenire sul microbiota intestinale potrebbe essere una strategia terapeutica promettente.
Immaginate di poter usare probiotici (batteri buoni), prebiotici (cibo per i batteri buoni) o sinbiotici (una combinazione dei due) per riequilibrare l’intestino, migliorare la produzione di SCFA come il butirrato, rinforzare la barriera intestinale e, di conseguenza, alleviare il carico su fegato e reni. Alcune meta-analisi recenti suggeriscono già benefici di questi approcci sia per la MASLD che per la CKD.

Certo, il nostro è uno studio “fotografico” (cross-sezionale), non possiamo stabilire un rapporto causa-effetto definitivo. Inoltre, abbiamo usato una tecnica (16S rRNA) che non dà dettagli a livello di ceppo batterico o funzioni specifiche, e non abbiamo raccolto dati dettagliati sulla dieta, che sappiamo influenzare tantissimo il microbiota. Serviranno studi futuri, magari longitudinali e con tecniche più avanzate come la metagenomica, per confermare e approfondire questi risultati.
Ma il messaggio chiave è forte e chiaro: l’intestino è un attore centrale nella partita che si gioca tra fegato grasso e malattia renale. La disbiosi e la barriera intestinale non sono uguali in queste due condizioni, e capire queste differenze potrebbe portarci a terapie più mirate e personalizzate in futuro. Un campo di ricerca davvero entusiasmante!
Fonte: Springer
